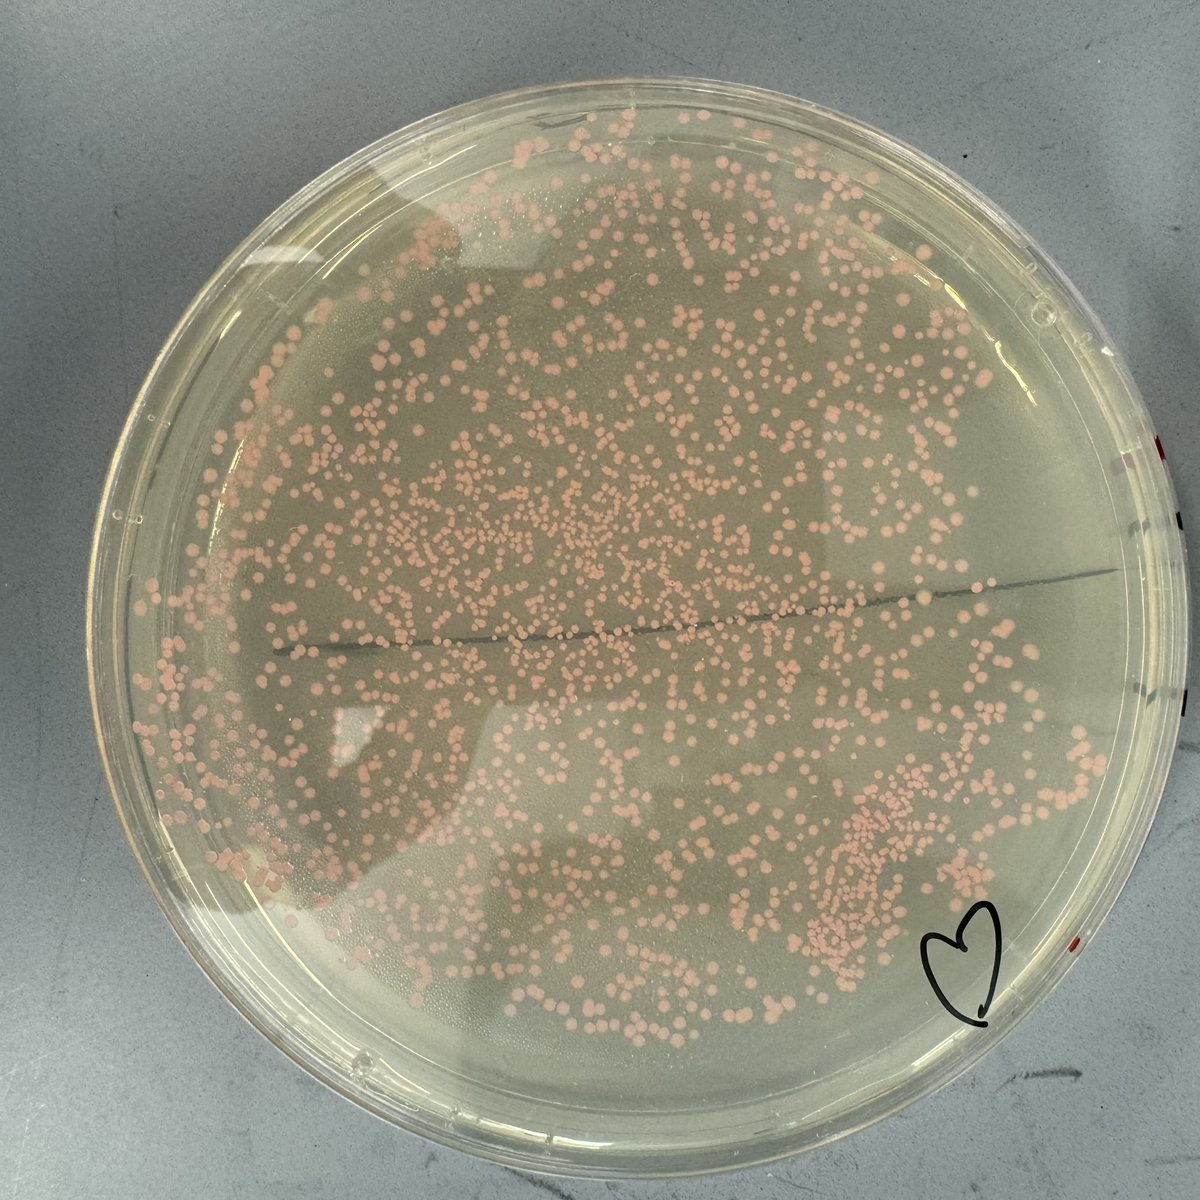
ABE Massachusetts tweet media

ABE MA Quick: Fall PDI @ MBL & Northeastern CPS with AI Support - mailchi.mp/9ee38891b847/p…


English
ABE Massachusetts
2.9K posts

@abe_mass
The Amgen Biotech Experience (ABE) Massachusetts Program Site @ABEProgOffice | Housed at the @Northeastern University - Innovation Campus

ABE has reached its 1 MILLIONTH STUDENT! We are amazed and proud at the way our program has grown to 27 sites and 16 countries around the globe, giving over 1M students the opportunity for hands-on biotech lab experience. Join us on Monday to celebrate! amgenbiotechexperience.com/abe-1mth-stude…



















Join us Tuesday, November 22 at noon ET for "Designing Universal Flu Vaccines," a virtual Cambridge Public Library talk featuring Daniel Lingwood @lingwoodlab. Registration is required: cambridgepl.libcal.com/event/9748696












